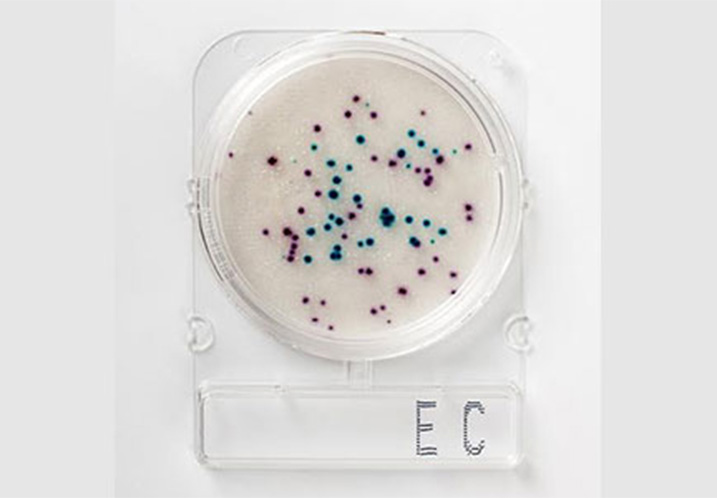
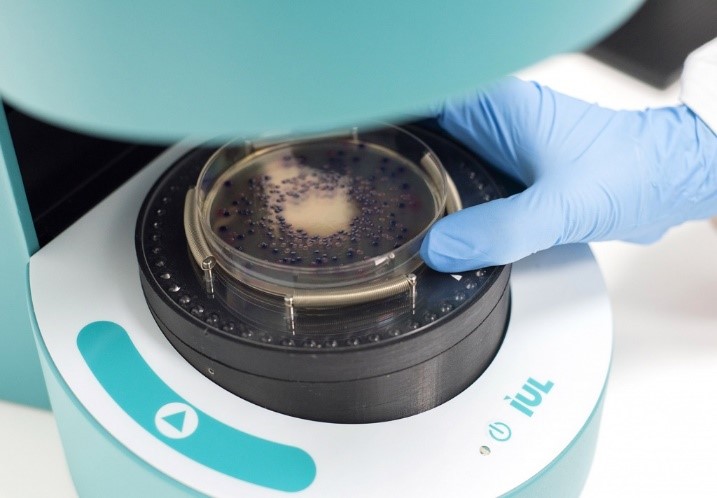

Why Almokhtabarat Al-Arabia Trading
Endeavoring to surpass client desires is our essential focal point of a quality administration framework so as to make abundance of information and involvement with improving the nature of human services, notwithstanding improving the access to diagnostics and early treatment; improve viability through proof-based practice; guarantee congruity of care.
Gaining an enormous advantage with new approaches in regards to innovative work, likewise the utilization of large information on understanding populaces to fortify patient commitment in regards to the item they experience whether through life sciences, medical diagnostics, vet and agro and/or food safety segments
We, Delta Trading and development ensure each and every item with extraordinary consideration, beginning from conveyance, through work, until indicating results and specialized help for a boundless period.
Our industry is the inventive driver for a therapeutic industry that, because of the move from block bluster items to customized prescription, presently relies upon new ideas. The generation of new medications utilizing hereditary building depends on information picked up from genomics, proteomics and frameworks science and makes new treatment methodologies that consolidate treatment and diagnostics, for example partner diagnostics to give a particular individualized treatment.
Featured Products